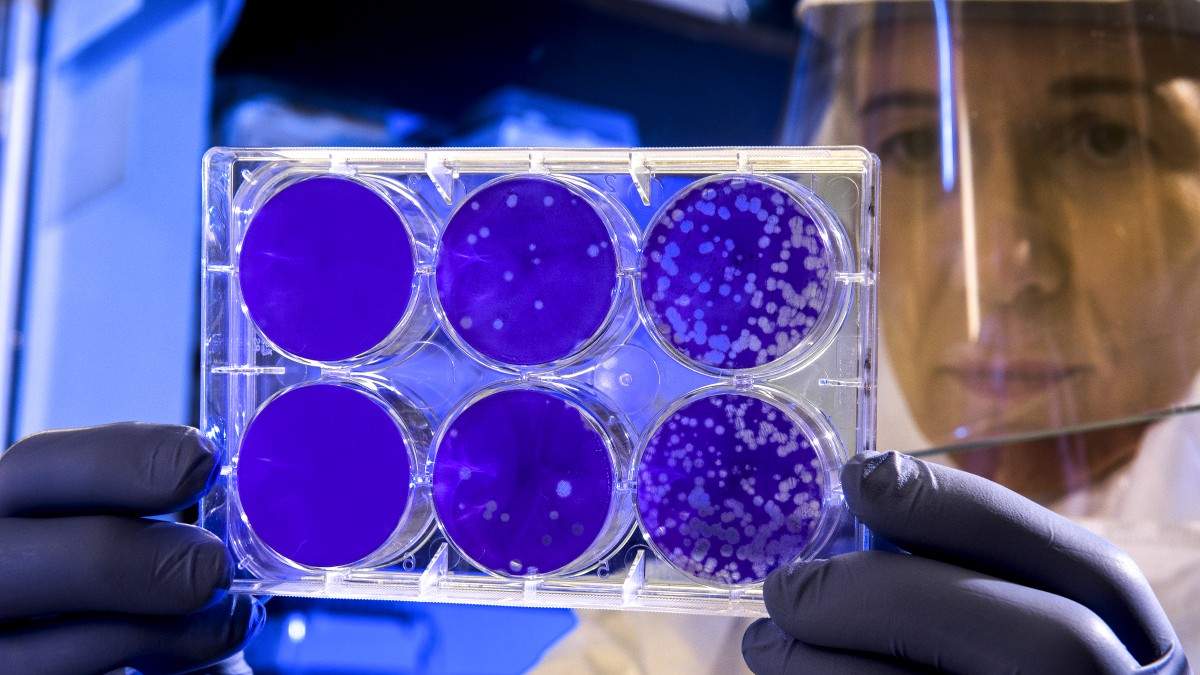

Δανία: Δύο μήνες φυλακή στην πρώην υπουργό Ενσωμάτωσης για τον χωρισμό ζευγαριών προσφύγων

Η πρώην υπουργός Ενσωμάτωσης της Δανίας καταδικάστηκε την Δευτέρα σε φυλάκιση δύο μηνών από ειδικό δικαστήριο, το οποίο έκρινε πως ήταν ένοχη για τον παράνομο χωρισμό ζευγαριών αιτούντων άσυλο όταν η γυναίκα ήταν ανήλικη. «Η Ίνγκερ Στόιμπεργκ κρίθηκε ένοχη για παραβίαση εκ προθέσεως (…) του νόμου περί ευθύνης υπουργών. Η ποινή είναι φυλάκιση 60 ημερών […]
Βραζιλία: Σαρωτικό προβάδισμα Λούλα έναντι του Μπολσονάρο «βλέπει» δημοσκόπηση

Ο κεντροαριστερός πρώην πρόεδρος της Βραζιλίας, ο Λουίς Ινάσιου Λούλα ντα Σίλβα, θα κέρδιζε με άνεση εάν οι προεδρικές εκλογές του Οκτωβρίου του 2022 διεξάγονταν χθες, καθώς το ποσοστό που εξασφαλίζει ο ακροδεξιός νυν πρόεδρος της χώρας της Λατινικής Αμερικής, ο Ζαΐρ Μπολσονάρο, έχει μειωθεί κατά σχεδόν τριάντα μονάδες, υπέδειξε δημοσκόπηση. Το 48% του δείγματος […]
Χονγκ Κονγκ: Εκατοντάδες εγκλωβισμένοι από πυρκαγιά στο Παγκόσμιο Κέντρο Εμπορίου

Τουλάχιστον 300 άνθρωποι υπολογίζεται ότι έχουν εγκλωβιστεί από την μεγάλη φωτιά που ξέσπασε στο Παγκόσμιο Κέντρο Εμπορίου στο Χονγκ Κονγκ, την Τετάρτη. Σύμφωνα με τις μέχρι στιγμής πληροφορίες, η φωτιά ξέσπασε στον πρώτο οροφο του ουρανοξύστη που στεγάζει εμπορικά καταστήματα, εστιατόρια και γραφεία και γρήγορα επεκτάθηκε. Οι δυνάμεις της πυροσβεστικής προσπαθούν να απομακρύνουν τον κόσμο […]
ΗΠΑ: Ξεπεράστηκε το ορόσημο των 800.000 θανάτων από κορονοϊό

Οι ΗΠΑ, επισήμως η χώρα που έχει υποστεί το βαρύτερο χτύπημα από την πανδημία του νέου κορονοϊού στην υφήλιο, ξεπέρασε χθες Τρίτη το τραγικό ορόσημο των 800.000 θανάτων εξαιτίας επιπλοκών της COVID-19, με βάση την καταμέτρηση του πανεπιστημίου Τζονς Χόπκινς. Ο αριθμός τους (επακριβώς 800.266 ως τη 01:22 ώρα Ελλάδας) είναι υψηλότερος από τον πληθυσμό […]
Μετάλλαξη Όμικρον: Η προειδοποίηση ΠΟΥ και το εφιαλτικό σενάριο της «υπερμετάλλαξης»
Ανησυχία προκαλούν οι προβλέψεις ορισμένων επιστημόνων, σχετικά με την εξέλιξη της πανδημίας και την εμφάνιση νέων παραλλαγών του ιού. Ο επικεφαλής γιατρός της Moderna, Πολ Μπάρτον, τόνισε πως ο μεγάλος αριθμός κρουσμάτων της νέας παραλλαγής Όμικρον, σε συνδυασμό με την ήδη υπάρχουσα Δέλτα αυξάνουν τον κίνδυνο για μια νέα υπερ – μετάλλαξη. Όπως είπε, κάτι […]
Είναι ο Έλον Μασκ πραγματικά το πρόσωπο της χρονιάς;

Μεγάλες αντιδράσεις προκάλεσε στις ΗΠΑ η επιλογή του γνωστού περιοδικού Time να αναδείξει τον δισεκατομμυριούχο και ισχυρό άνδρα της Tesla Έλον Μασκ, σε πρόσωπο της χρονιάς για το 2021. Ο Αμερικανός κροίσος –του οποίου η περιουσία φτάνει τα 300 δισ δολ, ξεπερνώντας και τον Τζεφ Μπέζο- έχει προκαλέσει επανειλημμένα με τις δημόσιες τοποθετήσεις του, τις […]
ΗΠΑ: 1 στους 100 Αμερικανούς άνω των 65 ετών πεθαίνει λόγω του κορονοϊού

Περίπου ο ένας στους εκατό Αμερικανούς και Αμερικανίδες που ανήκουν στην ηλικιακή κατηγορία άνω των 65 ετών έχασε τη ζωή του εξαιτίας της COVID-19, αποκαλύπτουν τα δεδομένα των Κέντρων Ελέγχου και Πρόληψης Ασθενειών (CDC), της κυριότερης ομοσπονδιακής υπηρεσίας δημόσιας υγείας των ΗΠΑ. Συνολικά 590.089 άνθρωποι ηλικίας 65 ετών και άνω έχουν υποκύψει εξαιτίας επιπλοκών της […]
Εφιαλτικές μνήμες ξύπνησε ο ισχυρός σεισμός 7,3 ρίχτερ στην Ινδονησία [Βίντεο]

Πανικό έσπειρε ο πολύ ισχυρός σεισμός μεγέθους 7,3 ρίχτερ που σημειώθηκε σήμερα στις 03.20 (05.20 ώρα Ελλάδος) στην Ινδονησία σε βάθος 18,5 χλμ. σε θαλάσσια περιοχή βόρεια του νησιού Φλόρες. Η σεισμολογική και μετεωρολογική υπηρεσία της Ινδονησίας εξέδωσε έκτακτο προειδοποιητικό δελτίο για τσουνάμι, σεισμικά θαλάσσια κύματα. Μέχρι στιγμής δεν έχουν αναφερθεί θύματα και σοβαρές υλικές […]
Oceanix City: Η πρώτη πλωτή πόλη στη Γη

H πρώτη βιώσιμη επιπλέουσα πόλη στον κόσμο είναι γεγονός. Η δημιουργία της υποστηρίζεται από τα Ηνωμένα Έθνη και αποτελεί μια απάντηση στην κλιματική κρίση και την επακόλουθη άνοδο της στάθμης της θάλασσας. Η συμφωνία υπεγράφη στις 18 Νοεμβρίου 2021 μεταξύ του δήμου της πόλης Busan στη Νότια Κορέα, του οργανισμού UN-Habitat (το πρόγραμμα των Ηνωμένων […]
ΗΠΑ: Εισήγηση για ποινική δίωξη σε «προσωπάρχη» του Τραμπ για την εισβολή στο Καπιτώλιο

Η ειδική εξεταστική επιτροπή της Βουλής των Αντιπροσώπων η οποία διενεργεί έρευνα για την αιματηρή επίθεση στο Καπιτώλιο της Ουάσινγκτον την 6η Ιανουαρίου τάχθηκε ομόφωνα (9-0) υπέρ της πρότασης να εισηγηθεί την άσκηση ποινικής δίωξης, για «περιφρόνηση» του Κογκρέσου και «παρακώλυση» του έργου του, στον Μαρκ Μέντοους, που υπήρξε γενικός γραμματέας («προσωπάρχης») της προεδρίας επί […]
